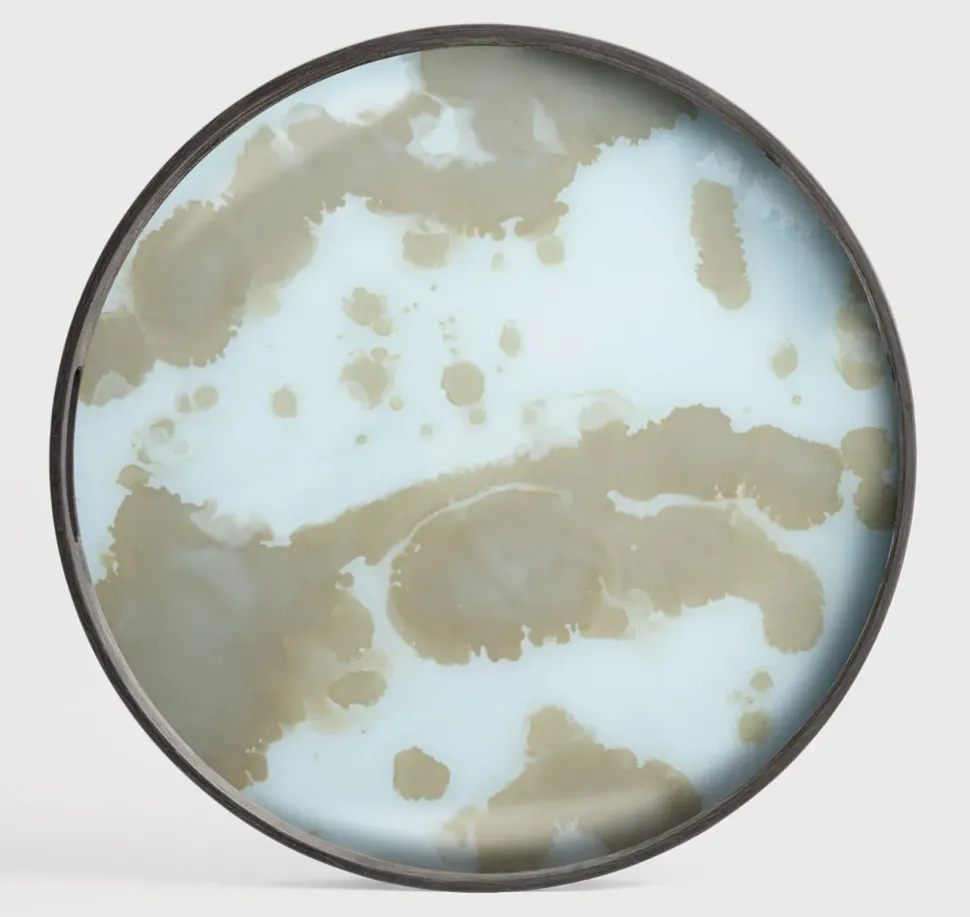

La collezione Mystic Gold, con il suo vassoio Organic in vetro, rappresenta una fusione perfetta di lusso e natura. I colori solari e l’oro esplosivo che caratterizzano ogni pezzo illuminano immediatamente qualsiasi ambiente, infatti il contrasto tra i bordi in legno e la base in vetro brillante mette in risalto le raffinate sfumature che dominano la serie.
Il vassoio Mist dipinto a mano, unisce eleganza e originalità ispirandosi alla natura per valorizzare la sua bellezza.
Materiali: Vetro e legno
Diamentro: 48cm
Altezza: 4cm
- Marca: Oggettistica Artigianale
- Modello:Vassoio in vetro e legno ethnicraft
- Materiale: vetro
- Stile: moderna
- Spese Trasporto: trasporto escluso
- Oggettistica Milano
- Outlet arredamento Milano
- Artigianale Milano
Bragazzi Interior Concept
Via Sempione 15
20016 Pero
Vassoio in vetro e legno ethnicraft Artigianale con uno sconto esclusivo
Grazie ai complementi e all’oggettistica d’arredo Artigianale potrai completare i locali interni della tua casa senza costi esagerati e assicurandoti un design unico. Accessori indispensabili e di grande carattere, gli accessori sono essenziali in qualsiasi progetto d’arredo. Nel nostro outlet troverai anche questo modello Vassoio in vetro e legno ethnicraft moderna, con uno sconto davvero vantaggioso.
Scegli l’elemento accessorio qui visibile
Il modello Vassoio in vetro e legno ethnicraft appartiene alla nostra collezione di oggettistica varia in vetro Artigianale, uno dei materiali più amati nel settore arredamento.
Se sei un amante delle ambientazioni in stile moderna non perderti questa proposta imperdibile e potrai completare i tuoi interni con l’elemento accessorio di Artigianale che hai sempre sognato.

Reviews
There are no reviews yet.